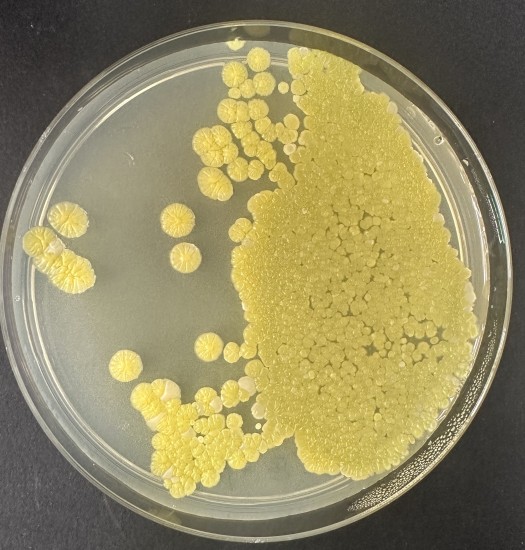

Name |
Streptomyces griseostramineus (Preobrazhenskaya et al. 1957) Pridham et al. 1958 |
|
Strain designation | ATCC 23628 |
|
Other collections | ATCC 19768; CBS 506.68; CCRC 12075; DSM 40161; ETH 28436; IFO 12781; INA 10381; ISP 5161; JCM 4385; KCC S-0385; Preobrazhenskaya 10381; RIA 1048 |
|
Access in situ (sampling data) | Source: Soil Country of access: Armenia Date of access: Before 11-12-1986 |
|
History | CECT, 1986 < ATCC < G.F. Gauze (Actinomyces griseostramineus) |
|
Growth conditions | Culture media: 118 Growth temperature (in °C): 30 Incubation time: 7d Atmospheric needs: aerobic Growth remarks: Variation in colonial morphology has been detected. Selection of colonies is not advised Cultivation conditions for CECT strains |
|
Restrictions | Risk group: 1 CECT MTA |
|
Genetic data | 16S rRNA sequence: AB184140 Complete genome sequence: jgi.1205656 |
|
Delivery | Freeze-dried culture | Acticult® 3R | Active culture rate A | Genomic DNA |
Tarifas de presentaciones |
|
Temperature: 30.0°C CECT Culture medium 118: Streptomyces sp. MEDIUM (6days) |
La CECT sigue estándares de calidad para garantizar la viabilidad, pureza y autenticidad de las cepas que conserva. La información mostrada en esta ficha procede de diversas fuentes. Algunas de las propiedades no han sido necesariamente contrastadas por la CECT |